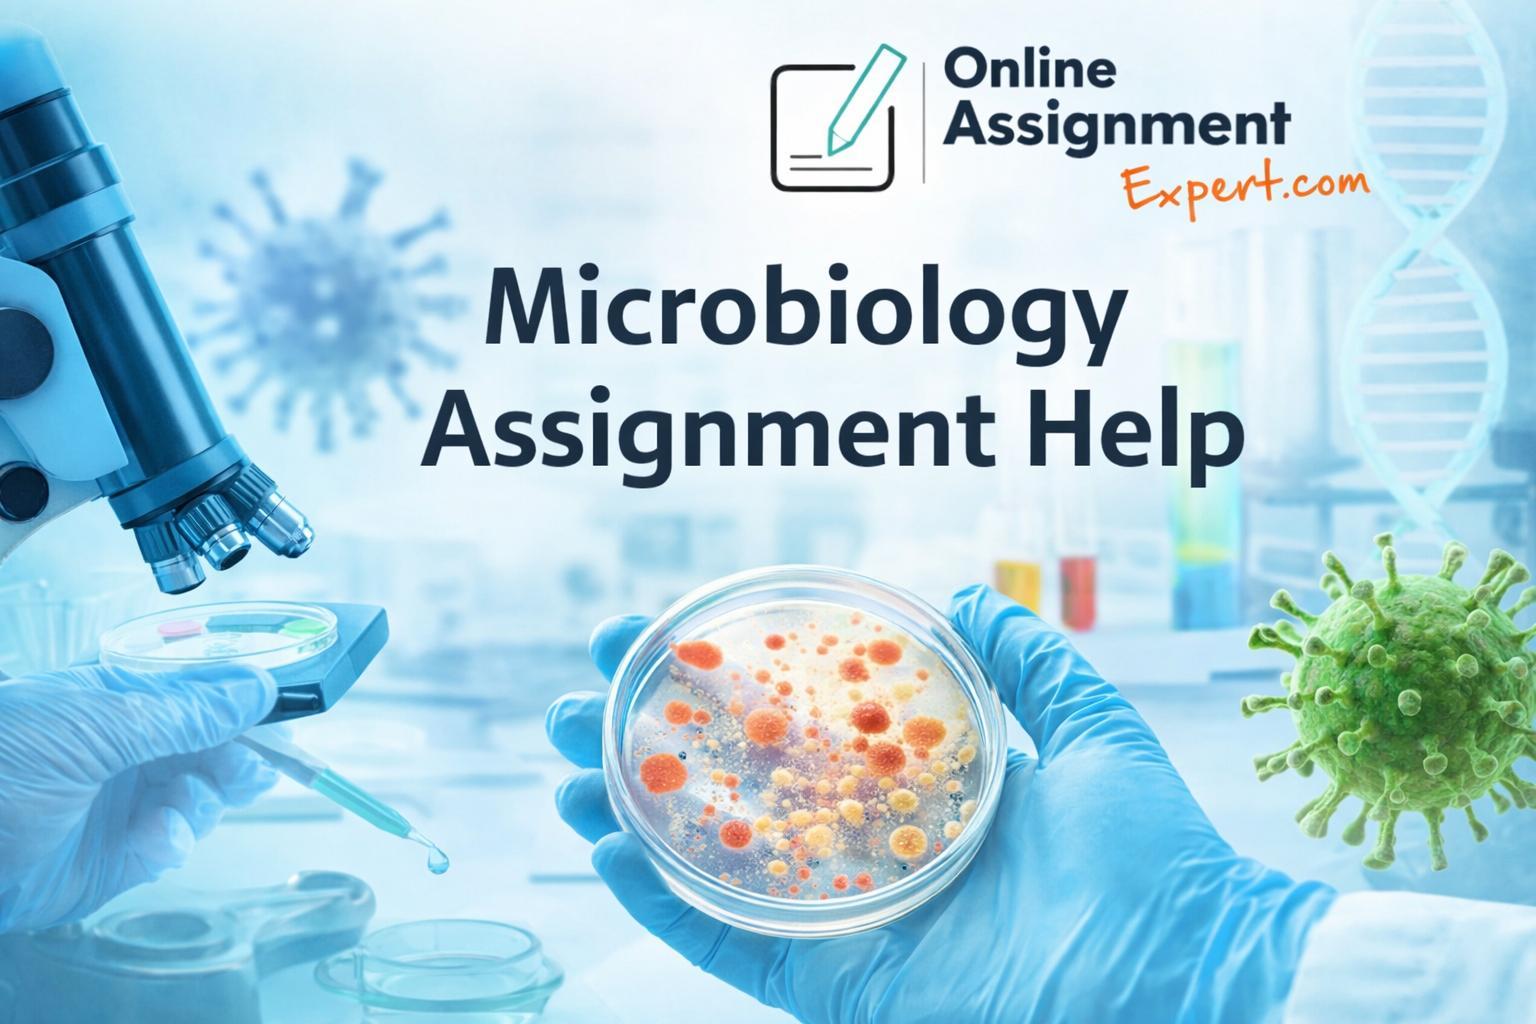

Expert Microbiology Assignment Help – Accurate, On-Time & Affordable
Struggling with complex topics like immunology, bacteriology, virology, or microbial genetics? Our Microbiology Assignment Help service is designed to support students with well-researched, plagiarism-free, and concept-accurate assignments. From lab reports and case studies to essays and dissertations, our subject-matter experts ensure clarity, proper referencing, and on-time delivery. Whether you’re facing tight deadlines or difficult concepts, our Microbiology Assignment Help offers reliable academic support at student-friendly prices, helping you score higher with confidence.
Visit here :
https://www.onlineassignment-expert.com/accounting/bookkeeping-assignment-help.htmExpert Microbiology Assignment Help – Accurate, On-Time & Affordable
Struggling with complex topics like immunology, bacteriology, virology, or microbial genetics? Our Microbiology Assignment Help service is designed to support students with well-researched, plagiarism-free, and concept-accurate assignments. From lab reports and case studies to essays and dissertations, our subject-matter experts ensure clarity, proper referencing, and on-time delivery. Whether you’re facing tight deadlines or difficult concepts, our Microbiology Assignment Help offers reliable academic support at student-friendly prices, helping you score higher with confidence.
Visit here : https://www.onlineassignment-expert.com/accounting/bookkeeping-assignment-help.htm